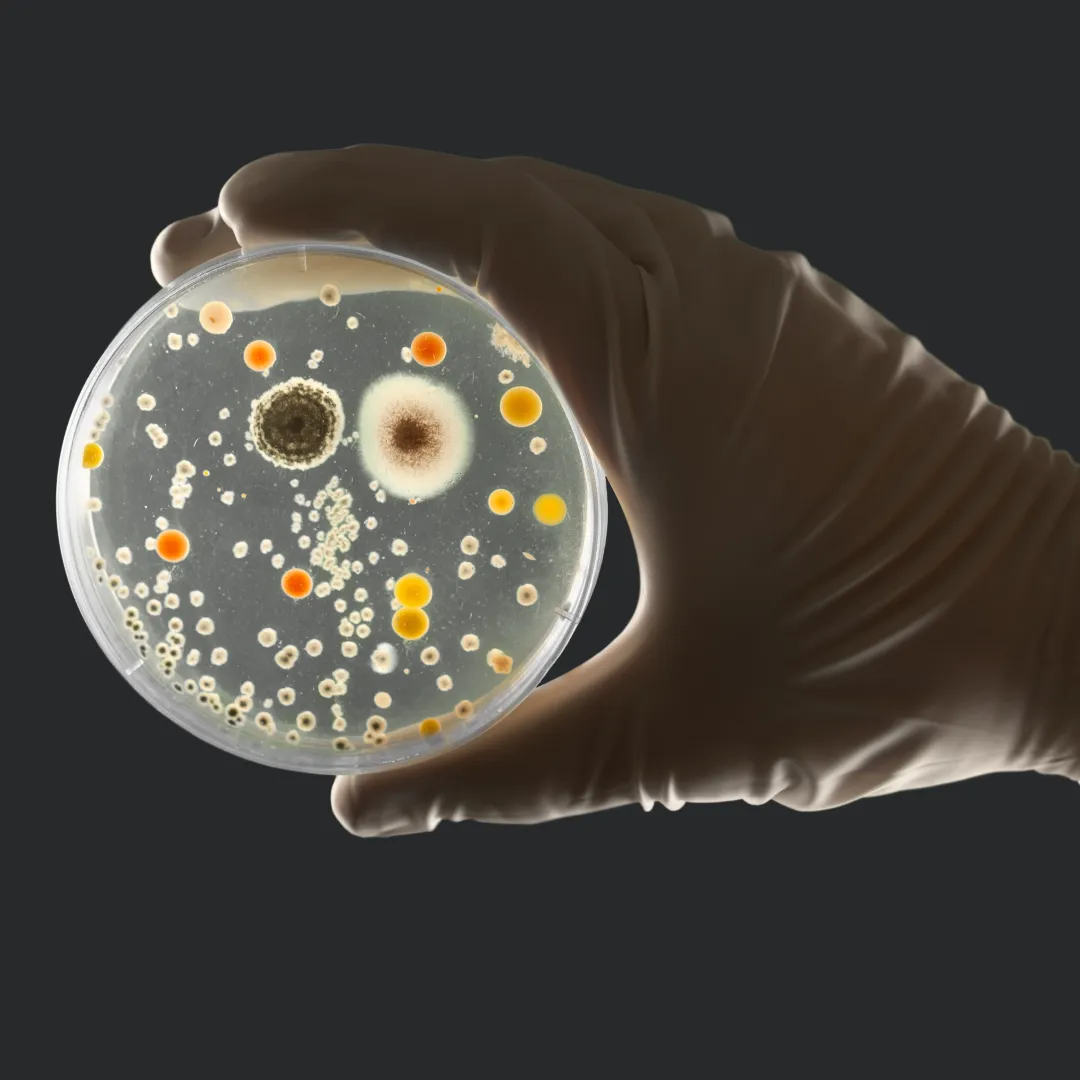

Take a tour to discover a path to wellness!


A daily double dose over six weeks empowers your system to combat stress, optimize health, and elevate your overall well-being.


A daily dose of each over six weeks supports sleep quality, relieve anxiety and overall wellness.

A daily double dose over six weeks empowers your system to combat stress, optimize health, and elevate your overall well-being.
A daily dose of each over six weeks supports sleep quality, relieve anxiety and overall wellness.
A daily dose of each over six weeks this dynamic duo enhances your overall well-being, cognitive function, and cardiovascular health.
Noni juice, rich in essential phytonutrients and antioxidants like Vitamin C and beta carotene, enhances immune modulation, boosts cell activity, and reduces oxidative stress.
Look at our HEAL Immunity Support Pack.


Premature Aging | Cellular Damage
Noni juice, loaded with potent antioxidants like Vitamin C, selenium, and beta-carotene, defends against cellular damage and DNA deterioration, rejuvenating your body at the cellular level. Explore our ENERGIZE Youth & Vitality Pack for comprehensive support against oxidative stress and to enhance your body's natural healing capabilities.
Experience the mental clarity and emotional balance afforded by Noni juice, a natural adaptogen known for its ability to stabilize mood, enhance brain health, and alleviate the effects of stress. Explore our BALANCE Tranquil Night Pack to nourish your mind and elevate your sense of wellness.

Toxin Overload | Bacterial Infections
Leverage the powerful detoxifying properties of Noni juice to cleanse your body, counteracting effects from harmful bacteria and reducing toxin levels, promoting a healthier, more vibrant you. Use the HEAL Immunity Support Pack to start healing today.
Harness the natural anti-inflammatory powers of Noni juice to combat chronic inflammation and alleviate joint pain, promoting healing and reducing discomfort with nature's own remedy. Explore our ENERGIZE Youth and Vitality Pack for targeted support against inflammation-driven ailments.


Sleep Deprivation | Cognitive Fatigue
Renowned for its mood-regulating and sleep-enhancing properties, Noni supports your brain health by stabilizing serotonin levels, promoting deep, restful sleep, and enhancing mental clarity and overall well-being. Use the BALANCE Tranquil Night Pack to start sleeping better.